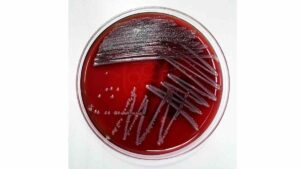
¿Qué es la bacteria Klebsiella oxytoca, culpable de la muerte de recién nacidos?

Miedo a las vacunas, una de las razones del rebrote de sarampión y tosferina en México
El secretario de salud, David Kershenobich, informó que, hasta el 1 de septiembre, en México se tienen registrados 4 mil 353 casos confirmados de sarampión y 17 personas fallecidas a causa de esta enfermedad, así lo indicó este martes durante la conferencia de prensa matutina de Presidencia.
Kershenobich destacó que la única manera de poder controlar el sarampión es la vacunación e indicó que actualmente, la cobertura de vacunación en México con un esquema completo es de 81.1%, cifra menor al 95% necesario para detener el brote de sarampión.
En el caso de la tosferina, el último Boletín Epidemiológico con fecha de corte al 23 de agosto, registró mil 364 casos causados por esta bacteria, lo que equivale a un aumento de más del 530% con respecto al número de pacientes registrados en la misma fecha pero de 2024.
Pero, ¿por qué hay un rebrote de tosferina y sarampión?
De acuerdo con el doctor Miguel Ángel Minero Hibert, infectólogo pediatra, los rebrotes de enfermedades contagiosas como el sarampión y la tosferina tiene que ver con varios factores, entre ellos, el miedo a las vacunas, los estragos de la pandemia de COVID-19 y la falta de información.
“La pandemia de COVID-19 sí trajo muchos retrasos en que las personas acudieran a vacunarse. Esto también implicó que hubiera un acceso menor a las vacunas, hubiera una menor adquisición de vacunas por que no se estaban fabricando por el tema de la pandemia y todo esto en un círculo es un factor importante”, aseguró Minero Hibert, este martes en entrevista con Unotv.com.
Otro factor que ha influido en que exista un rebrote de tosferina y sarampión en México es que “a veces las vacunas nos llegan a poder generar dudas”. No obstante, el especialista enfatizó que “las vacunas son seguras, son efectivas, y tienen muchos estudios y evidencias que las respaldan para poderlas recomendar”.
“Nosotros como médicos siempre vamos a buscar el beneficio de nuestros pacientes y si nosotros sabemos que una vacuna le va a dar ese beneficio de protegernos de morir, de presentar una complicación, siempre las vamos a recomendar”.
Miguel Ángel Minero Hibert, infectólogo pediatra
Acceso inequitativo a la vacunación
El acceso inequitativo a las vacunas, es también un factor que influye en que haya rebrotes de enfermedades infectocontagiosas como el sarampión y la tosferina.
Esta falta de acceso puede darse, por un lado, por la falta de vacunas en las distintas unidades de salud, pero también por no completar los cuadros de vacunación señalados.
“Siempre tenemos que completar los esquemas. Si la cartilla dice cuatro dosis, son cuatro. si dice dos, son dos. Porque también dejarlas incompletas hace que resurjan las demás enfermedades”
Miguel Ángel Minero Hibert, infectólogo pediatra
Las vacunas son una necesidad, no un negocio
Las vacunas con las que se cuentan en el sector salud son buenas, independientemente de la casa comercial que las fabrique, independientemente de la marca. Todas las vacunas tienen un propósito, que es prevenir una enfermedad o complicación.
“Nosotros como médicos no las recomendamos porque recibamos algún beneficio o estemos asociados a una industria. Simplemente lo que hacemos, como parte de nuestro juramento hipocrático que hacemos en la carrera, pues es evidentemente recomendar este tipo de prevenciones porque sabemos el impacto que generan y sabemos que podemos cambiarle la vida a un bebé, a un niño, inclusive hasta a un un adulto mayor”
Miguel Ángel Minero Hibert, infectólogo pediatra
Ante cualquier duda, Minero Hilbert sugirió acercarse con un profesional de la salud, quien es el más indicado para responder todas las preguntas acerca de la vacunación y recomendar siempre la mejor opción para cada paciente.
“Detrás de una enfermedad prevenible por vacunación está una familia que requiere gastar más en algún recurso, en algún tratamiento o en ausentismo laboral“, concluyó el experto.
Te recomendamos:

Salud
Anuncian el Café Bienestar: ¿cuáles son sus posibles beneficios a la salud?
Salud
¿Qué es la bacteria Klebsiella oxytoca, culpable de la muerte de recién nacidos?

Salud
Té de jengibre con limón: ¿cuáles son sus beneficios y propiedades curativas?

